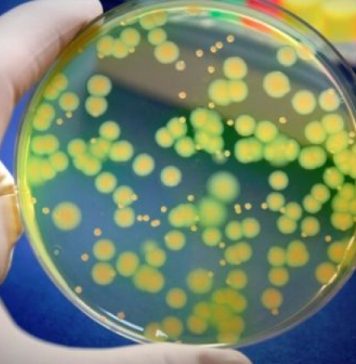
STUDIU/ Bolnavii de SIDA, ameninţaţi de o formă gravă de Mpox

Un număr de 12.688 de persoane cu COVID-19 sunt internate în unităţile sanitare de profil, dintre care 1.076 la terapie intensivă, cel mai mare număr de până acum, a informat, luni, Grupul de Comunicare Strategică (GCS). Pe teritoriul României, 41.024 de persoane confirmate cu infecţie cu noul coronavirus sunt în izolare la domiciliu şi 24.762 se află în izolare instituţionalizată. De asemenea, 72.980 de persoane se află în carantină la domiciliu, iar 19 în carantină instituţionalizată.

Proiectul jurnalistic pressonline.ro este un proiect susținut de AGI
- o asociație neguvernamentală, apolitică și non-profit.
- o asociație neguvernamentală, apolitică și non-profit.
Depinde și de tine să susții o presă independentă.